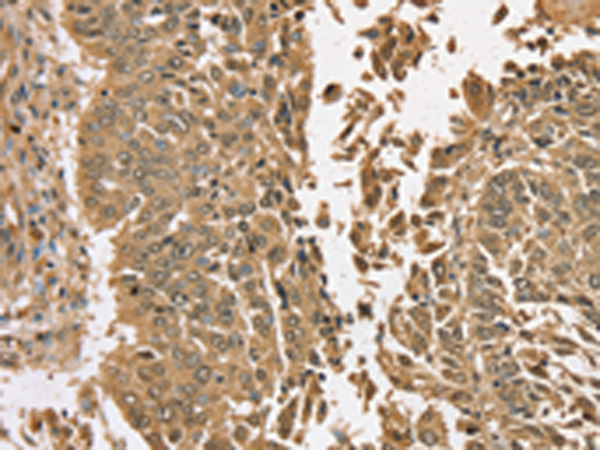

-
分类: 科研抗体货号: P12309别名: APRIL; CD256; TALL2; ZTNF2; TALL-2; TRDL-1; UNQ383/PRO715应用: IHC反应种属: Human, Mouse
-
分类: 科研抗体货号: P12310别名: TL1; TL1A; VEGI; VEGI192A应用: WB,IHC反应种属: Human, Mouse, Rat
-
分类: 科研抗体货号: P12326别名: CSRP; RGR1; CRSP2; EXLM1; CXorf4; CRSP150; DRIP150; TRAP170应用: IHC反应种属: Human
-
分类: 科研抗体货号: P12307别名: DFNB8; DFNB10; ECHOS1; TADG12应用: IHC反应种属: Human, Mouse
-
分类: 科研抗体货号: P12325别名: OKS; FGS1; HOPA; OPA1; OHDOX; ARC240; CAGH45; MED12S; TNRC11; TRAP230应用: IHC反应种属: Human, Mouse
-
分类: 科研抗体货号: P12305别名: EPG3; TANGO5; TMEM49应用: WB,IHC反应种属: Human, Mouse, Rat
-
分类: 科研抗体货号: P12323别名: TG6; TGY; SCA35; TGM3L; dJ734P14.3应用: IHC反应种属: Human
-
分类: 科研抗体货号: P12303别名: TR; HPP1; TPEF; TENB2; CT120.2应用: IHC反应种属: Human, Mouse
-
分类: 科研抗体货号: P12322别名: LI; KTG; LI1; TGK; ICR2; ARCI1; TGASE应用: IHC反应种属: Human
-
分类: 科研抗体货号: P12302别名: MP70; HMP70应用: IHC反应种属: Human, Mouse, Rat

鄂公网安备42018502007531号
鄂公网安备42018502007531号

